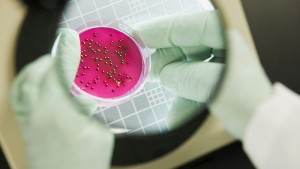
бактерии

Технологии
Актуални новини от Технологии. Посетете нашата секция с новини от Технологии Сега!
11.07.2017
Еволюционно решение: Черва пренасят кръвта и кислорода в морски паяк
За разлика от повечето животни, морските паяци не се осланят на биене на сърцето, за ...
07.07.2017
Майк Пенс обяви нова космическа ера за САЩ
Вицепрезидентът на САЩ Майк Пенс говори в сряда за появата на "нова ера" в изследването ...
02.07.2017
Китай строи първия "град-гора" (СНИМКИ/ВИДЕО)
Строежът на първия "град-гора" в света започна близо до град Лючжоу в Гуанси, Китай, ...
28.06.2017
Китай спусна на вода разрушител с управляеми ракети
Днес Китай спусна на вода разрушител (ескадрен миноносец), въоръжен с управляеми ракети ...
25.06.2017
Обясниха стълбовете горяща плазма в слънчевата атмосфера
Американски и норвежки учени успяха да обяснят формирането на тънки стълбове горяща ...
24.06.2017
Нов руски военен спътник ще контролира космически обекти
Изстреляният в петък вечерта "Космос-2519" ще снима космически обекти, съобщи военното ...
24.06.2017
Рибата зебра изуми учени
Американски учени откриха уникален механизъм за възстановяване на гръбначния стълб ...
23.06.2017
Сателитът BulgariaSat-1 бе изведен успешно на орбита (СНИМКИ/ВИДЕО)
Първият български частен геостационарен комуникационен сателит бе изведен успешно ...
20.06.2017
Какви автомобили карат българите?
Малко над 400 леки автомобила се падат на 1000 жители в България, сочат данни от анализ ...
18.06.2017
Народното събрание с нов сайт
Народното събрание модернизира сайта си parliament.bg. Освен че на него вече се качват значително ...
18.06.2017
Уличен художник изрисува най-големия графит в Европа (ВИДЕО)
Дрон успя да запечата най-големият графит. Платното се намира в руския град Викса, област ...
17.06.2017
Русия прави изкуствени острова в Баренцово море, ще строи морски съоръжения
Руският премиер Дмитрий Медведев подписа нареждане, предвиждащо в Колския залив на ...
16.06.2017
И жени в руския експеримент СИРИУС
Най-малко две жени ще бъдат сред шестимата участници в експеримента "СИРИУС", при който ...
14.06.2017
Как дронове ще спасяват човешки животи?
Дронове, които скоро вероятно ще доставят пакети в домовете, имат потенциала да спасят ...
12.06.2017
Как се правят кренвиршите? (ВИДЕО)
Как и от какво се правят кренвиршите е тема, която от години е в дневния ред на българина. ...
11.06.2017
Минихеликоптер се движи по шосе (СНИМКИ/ВИДЕО)
Докато производители на коли в цял свят се състезават кой първи ще изкара на пазара ...
11.06.2017
Кометите донесли голямо количество ксенон на Земята
Международен екип от учени обясни произхода в атмосферата на Земята на ксенона - благороден ...
10.06.2017
От кога Рилският манастир се намира в... София? (СНИМКИ)
Коя е първата снимка, която ще ви се покаже, ако в "изображения" в световната търсачка ...
09.06.2017
Представители на най-старата цивилизация са живели във Врачанско
Представители на най-старата човешка цивилизация са живели във Врачанско преди близо ...
05.06.2017
Учени разкриват тайните на сигналите от "извънземните" цивилизации
Китайски и американски учени изказаха предположение за същността на физическия процес, ...
04.06.2017
Разкриха тайната на кратерите на дъното на Баренцово море
Норвежки геофизици установиха, че гигантските кратери на дъното на Баренцово море ...
02.06.2017
Изчислиха кога изкуственият интелект ще замени човека
Изследователи от Института за бъдещето на човечеството в Оксфордския университет ...
01.06.2017
САЩ построиха най-големия самолет в света (ВИДЕО/СНИМКИ)
В сряда САЩ показаха най-големия самолет в света "Стратолаунч".
Той е създаден да ...
31.05.2017
Френският астронавт Песке се връща на Земята (ВИДЕО/СНИМКИ)
Френският астронавт Томас Песке, който вече си е приготвил куфарите за връщането на ...
31.05.2017
"Ягуар" е готов с най-екстремната суперкола в историята си
Британската компания Jaguar Land Rover представи прототип на спортния седан Jaguar XE SV Project 8.
Автомобилът ...
30.05.2017
Робот полицай на работа в Дубай (СНИМКИ/ВИДЕО)
Първият хуманоиден робот се присъединява към силите на реда на Дубай. Той бе представен ...
29.05.2017
Япония създава свръхточна система за космическо позициониране
Правителството на Япония създава напълно автономна система за регионално космическо ...
29.05.2017
Разкриха ли авторите на вируса WannaСry?
Експерти по компютърна сигурност установиха, че създателите на вируса рекетьор "Уонакрай" ...
26.05.2017
Роскосмос допуска: може да има следи от извънземен живот по повърхността на МКС
Следи от извънземен живот може да има по външната повърхност на Международната космическа ...
26.05.2017
Откриха артефакти от много древна цивилизация в Перу (СНИМКИ)
Американски археолози откриха на тихоокеанското крайбрежие в северната част на Перу ...
25.05.2017
В Словения поставиха първата дигитална надгробна плоча (СНИМКИ)
В гробището на словенския град Марибор беше поставена първата дигитална плоча над ...
25.05.2017
Има ли полза от фитнес тракерите?
Милиони хора по света използват спортни гривни, часовници или други подобни устройства, ...
24.05.2017
Учени идентифицираха нов източник за съществуване на извънземен живот
Облъчената с радиация вода е потенциална жизнена среда за извънземни микроорганизми, ...
24.05.2017
2349 сайта по света с домейн на кирилица
Над 2349 уебстраници по света са регистрирани с разширение .ею - домейн на кирилица, който ...
24.05.2017
Кога човекът ще може да стигне до най-близките до Слънцето звезди?
Астрофизикът Рене Хелер от института "Макс Планк" за изследване на Слънчевата система ...
21.05.2017
Представиха най-тънката холограма
Учени от Китай и Австралия създадоха най-тънката холограма, съобщи ЮПИ. Един ден технологията ...
21.05.2017
Бъдещето пред хората: Живот в кафези
Шведска архитектурна фирма предложи да се откажем от строителството на домове върху ...
21.05.2017
Стивън Хокинг: Трябва да си намерим нов дом на друга планета (ВИДЕО)
Британският физик теоретик Стивън Хокинг отново предупреди, че оцеляването на човечеството ...
20.05.2017
Руски учени разработват алтернативна на антибиотиците
Руските учени са на път да развият нов клас лекарства, които ще бъдат алтернатива на ...
19.05.2017
Как баща и син превърнаха руска "Лада" в робот от "Трансформърс" (ВИДЕО)
Баща и син, вдъхновени от филма "Трансформърс", създадоха свой собствен автомобилен ...